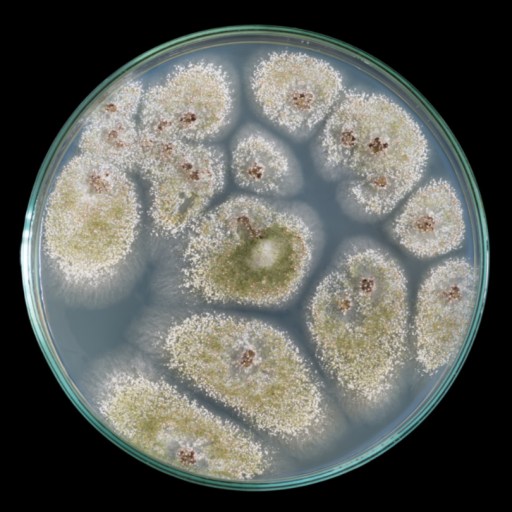

Search
Robby Berman
Contributing Writer
I’m a writer, musician, and father living in central New York with my wife, two daughters, one dog, two cats, and countless questions. I’m especially interested in animal rights, creativity, politics, the nature of things and time, and in making a worthwhile contribution. You can follow me @everyrobby.
Read Less

As songwriters, The Beatles had a special trick for making lyrics resonate: They leveraged the power of personal pronouns to connect with listeners.

Michio Kaku reminds us that with wonderful new technologies come not-so-wonderful unexpected uses for them.

Casual sex isn't as mindless as it seems, with people actually looking for love, and influenced by brain chemistry and genes.
Neil deGrasse Tyson says the best way to get children interested in science is to get out of their way, or give them some binoculars.

